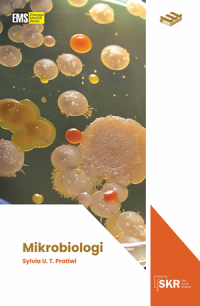
Image of Seri Kuliah Ringkas : Mikrobiologi

Textbook
Seri Kuliah Ringkas : Mikrobiologi
Buku ini membahas tentang :
Bab 1. Pendahuluan: Biologi Mikroorganisme
Bab 2. Genetika Mikroorganisme
Bab 3. Interaksi dan Ekologi Mikroba
Bab 4. Pertumbuhan Mikroba
Bab 5. Kontrol Pertumbuhan Mikroba
Bab 7. Patogenisitas Mikroba
Ketersediaan
#
Rak C. Sisi Kiri. Perpustakaan STIKVINC (C.23 (Mikrobiologi))
616.01 Pra s
12155
Tersedia
Informasi Detail
- Judul Seri
-
-
- No. Panggil
-
616.01 Pra s
- Penerbit
- Jakarta : Erlangga., 2023
- Deskripsi Fisik
-
xiii, 162 hlm. ; ilus ; bibl ; indeks ; 15,5 x 24
- Bahasa
-
Indonesia
- ISBN/ISSN
-
978-623-180-199-9
- Klasifikasi
-
616.01
- Tipe Isi
-
-
- Tipe Media
-
-
- Tipe Pembawa
-
-
- Edisi
-
-
- Subjek
- Info Detail Spesifik
-
-
- Pernyataan Tanggungjawab
-
Sylvia Utami Tunjung Pratiwi ; Ed : Rina Astikawati ; Evie Kemala Dewi
Versi lain/terkait
Tidak tersedia versi lain
Lampiran Berkas
Tidak Ada Data
Komentar
Anda harus masuk sebelum memberikan komentar
Karya Umum
Karya Umum  Filsafat
Filsafat  Agama
Agama  Ilmu-ilmu Sosial
Ilmu-ilmu Sosial  Bahasa
Bahasa  Ilmu-ilmu Murni
Ilmu-ilmu Murni  Ilmu-ilmu Terapan
Ilmu-ilmu Terapan  Kesenian, Hiburan, dan Olahraga
Kesenian, Hiburan, dan Olahraga  Kesusastraan
Kesusastraan  Geografi dan Sejarah
Geografi dan Sejarah